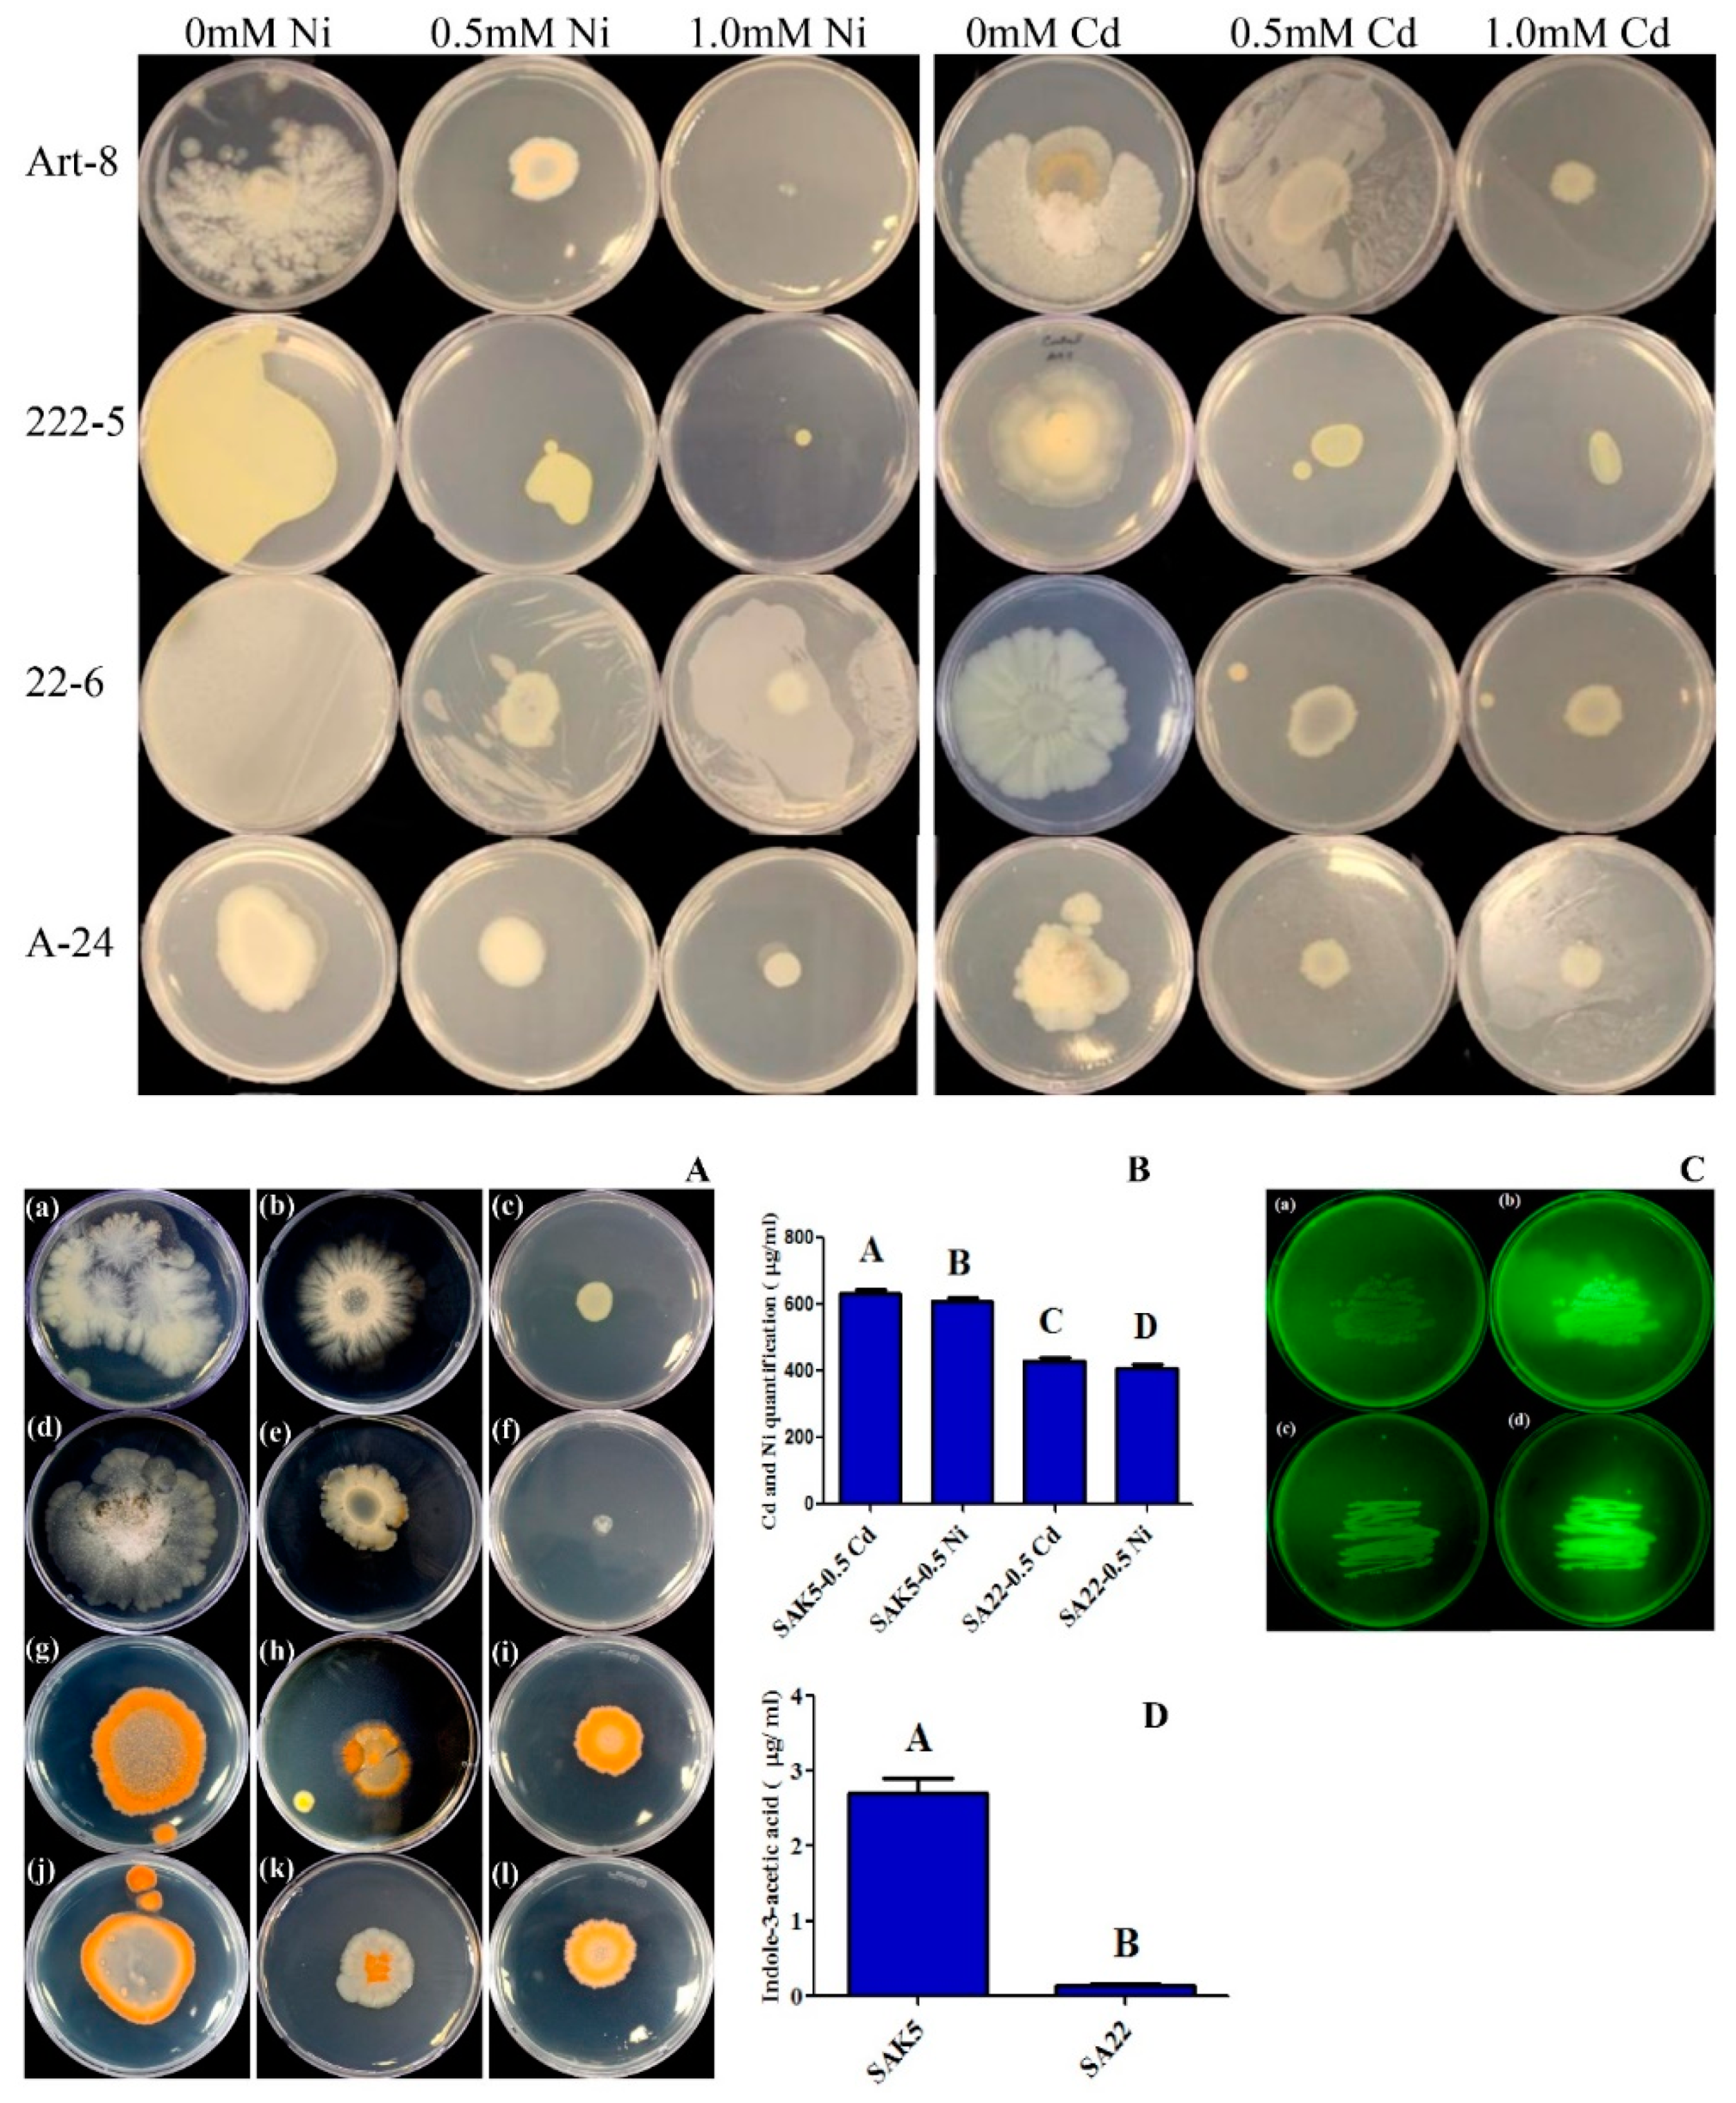
Plants 08 00363 g001 Plants 08 00363 g001

Metal Resistant Endophytic Bacteria Reduces Cadmium, Nickel Toxicity, and Enhances Expression of Metal Stress Related Genes with Improved Growth of Oryza Sativa, via Regulating Its Antioxidant Machinery and Endogenous Hormones
Abstract
1. Introduction
2. Materials and Methods
2.1. Isolation, Screening, Bioassay, and Identification of Bacterial Endophytes
2.2. Quantification of In Vitro IAA by Gas Chromatography-Mass Spectrometry/Selective Ion Monitoring (GC-MS/SIM)
2.3. Glutathione Production Assessment with Monochlorobimane (MCB)
2.4. Hydroponic Experimental Setup and Growth Conditions
2.5. Assessment of Growth Parameters under Cd and Ni Stress
2.6. RNA Isolation and qPCR Analysis of Selected Genes
2.7. Cd and Ni Uptake Analysis by Inductively Coupled Plasma Mass Spectrometry (ICP-MS)
2.8. ABA and SA Accumulation under Cd and Ni Stress
2.9. Free Amino Acid (FAA) Quantification
2.10. Estimation of Soluble Sugars
2.11. Statistical Analysis
3. Results
3.1. Screening of Endophytic Bacteria for Heavy Metal Stress and Glutathione Biosynthesis
3.2. IAA Quantification in the Culture Broth of Selected Isolates
3.3. Evaluation of Phenotypic Attributes and Chlorophyll Content under Cd and Ni Stress
3.4. Gene Regulation under Heavy Metal Stress
3.5. Cd and Ni Accumulation and Translocation to Shoots
3.6. Regulation of ABA and SA under Cd and Ni Stress Coupled with PGPB
3.7. Heavy Metal Stress Regulation of Proline Biosynthesis
3.8. Quantitative Analysis of Sugar Content
4. Discussion
5. Conclusions
Supplementary Materials
Author Contributions
Funding
Conflicts of Interest
References
- Duffus, J.H. “Heavy metals” a meaningless term? (IUPAC Technical Report). Pure Appl. Chem. 2002, 74, 793–807. [Google Scholar] [CrossRef]
- He, Z.L.; Yang, X.E.; Stoffella, P.J. Trace elements in agroecosystems and impacts on the environment. J. Trace Elem. Med. Boil. 2005, 19, 125–140. [Google Scholar] [CrossRef] [PubMed]
- Muchuweti, M.; Birkett, J.; Chinyanga, E.; Zvauya, R.; Scrimshaw, M.; Lester, J. Heavy metal content of vegetables irrigated with mixtures of wastewater and sewage sludge in Zimbabwe: Implications for human health. Agric. Ecosyst. Environ. 2006, 112, 41–48. [Google Scholar] [CrossRef]
- Gratão, P.L.; Polle, A.; Lea, P.J.; Azevedo, R.A. Making the life of heavy metal-stressed plants a little easier. Funct. Plant Boil. 2005, 32, 481. [Google Scholar] [CrossRef]
- Breckle, S.W.; Kahle, H. Effects of toxic heavy metals (Cd, Pb) on growth and mineral nutrition of beech (Fagus sylvatica L.). Vegetatio 1992, 101, 43–53. [Google Scholar] [CrossRef]
- Becerril, J.M.; Munoz-Rueda, A.; Aparicio-Tejo, P.; Gonzalez-Murua, C. The effects of cadmium and lead on photosynthetic electron transport in clover and lucerne. Plant Physiol. Biochem. 1988, 26, 357–363. [Google Scholar]
- Keck, R.W. Cadmium Alteration of Root Physiology and Potassium Ion Fluxes. Plant Physiol. 1978, 62, 94–96. [Google Scholar] [CrossRef] [PubMed]
- Greger, M.; Lindberg, S. Effects of Cd2+ and EDTA on young sugar beets (Beta vulgaris). I. Cd2+ uptake and sugar accumulation. Physiol. Plant. 1986, 66, 69–74. [Google Scholar] [CrossRef]
- Homma, Y.; Hirata, H. Kinetics of cadmium and zinc absorption by rice seedling roots. Soil Sci. Plant Nutr. 1984, 30, 527–532. [Google Scholar] [CrossRef]
- Ros, R.; Morales, A.; Segura, J.; Picazo, I. In vivo and in vitro effects of nickel and cadmium on the plasmalemma ATPase from rice (Oryza sativa L.) shoots and roots. Plant Sci. 1992, 83, 1–6. [Google Scholar] [CrossRef]
- Sharma, A.; Dhiman, A. NICKEL AND CADMIUM TOXICITY IN PLANTS. J. Pharm. Sci. Innov. 2013, 2, 20–24. [Google Scholar] [CrossRef]
- Stohs, S. Oxidative mechanisms in the toxicity of metal ions. Free Radic. Boil. Med. 1995, 18, 321–336. [Google Scholar] [CrossRef]
- Mitra, R.S. Protein synthesis in Escherichia coli during recovery from exposure to low levels of Cd2+. Appl. Environ. Microbiol. 1984, 47, 1012–1016. [Google Scholar] [PubMed]
- Hernandez, L.E.; Carpena-Ruiz, R.; Gárate, A. Alterations in the mineral nutrition of pea seedlings exposed to cadmium. J. Plant Nutr. 1996, 19, 1581–1598. [Google Scholar] [CrossRef]
- Balestrasse, K.B.; Benavides, M.P.; Gallego, S.M.; Tomaro, M.L. Effect of cadmium stress on nitrogen metabolism in nodules and roots of soybean plants. Funct. Plant Boil. 2003, 30, 57–64. [Google Scholar] [CrossRef]
- Fodor, E.; Szabó-Nagy, A.; Erdei, L. The Effects of Cadmium on the Fluidity and H+-ATPase Activity of Plasma Membrane from Sunflower and Wheat Roots. J. Plant Physiol. 1995, 147, 87–92. [Google Scholar] [CrossRef]
- Das, P.; Samantaray, S.; Rout, G.R. Studies on cadmium toxicity in plants: a review. Environ. Pollut. 1997, 98, 29–36. [Google Scholar] [CrossRef]
- Sheoran, I.S.; Singal, H.R.; Singh, R. Effect of cadmium and nickel on photosynthesis and the enzymes of the photosynthetic carbon reduction cycle in pigeonpea (Cajanus cajan L.). Photosynth. Res. 1990, 23, 345–351. [Google Scholar] [CrossRef]
- Farago, M.E.; Mullen, W.A. Plants which accumulate metals. Part IV. A possible copper-proline complex from the roots of Armeria maritima. Inorg. Chim. Acta 1979, 32, L93–L94. [Google Scholar] [CrossRef]
- Costa, G.; Morel, J.L.U. Water relations, gas exchange and amino acid content in Cd-treated lettuce. Plant Physiol. Biochem. 1994, 32, 561–570. [Google Scholar]
- Wu, J.T.; Hsieh, M.T.; Kow, L.C. ROLE OF PROLINE ACCUMULATION IN RESPONSE TO TOXIC COPPER IN CHLORELLA SP. (CHLOROPHYCEAE) CELLS. J. Phycol. 1998, 34, 113–117. [Google Scholar] [CrossRef]
- Michalak, A. Phenolic Compounds and Their Antioxidant Activity in Plants Growing under Heavy Metal Stress. Pol. J. Environ. Stud. 2006, 15, 523–530. [Google Scholar]
- Grill, E.; Löffler, S.; Winnacker, E.L.; Zenk, M.H. Phytochelatins, the heavy-metal-binding peptides of plants, are synthesized from glutathione by a specific gamma-glutamylcysteine dipeptidyl transpeptidase (phytochelatin synthase). Proc. Natl. Acad. Sci. USA 1989, 86, 6838–6842. [Google Scholar] [CrossRef] [PubMed]
- Kagi, J.H. Overview of metallothionein. Methods Enzymol. 1991, 205, 613–626. [Google Scholar] [PubMed]
- Zhao, D.; Li, T.; Shen, M.; Wang, J.; Zhao, Z. Diverse strategies conferring extreme cadmium (Cd) tolerance in the dark septate endophyte (DSE), Exophiala pisciphila: Evidence from RNA-seq data. Microbiol. Res. 2015, 170, 27–35. [Google Scholar] [CrossRef] [PubMed]
- Liu, Y.J.; Han, X.M.; Ren, L.L.; Yang, H.L.; Zeng, Q.Y. Functional divergence of the glutathione S-transferase supergene family in Physcomitrella patens reveals complex patterns of large gene family evolution in land plants. Plant Physiol. 2013, 161, 773–786. [Google Scholar] [CrossRef] [PubMed]
- Mannervik, B. Five Decades with Glutathione and the GSTome. J. Boil. Chem. 2012, 287, 6072–6083. [Google Scholar] [CrossRef]
- Morel, M.; Ngadin, A.A.; Droux, M.; Jacquot, J.P.; Gelhaye, E. The fungal glutathione S-transferase system. Evidence of new classes in the wood-degrading basidiomycete Phanerochaete chrysosporium. Cell. Mol. Life Sci. 2009, 66, 3711–3725. [Google Scholar] [CrossRef] [PubMed]
- Rauser, W. Phytochelatins and related peptides. Structure, biosynthesis, and function. Plant Physiol. 1995, 109, 1141–1149. [Google Scholar] [CrossRef]
- Wawrzyński, A.; Kopera, E.; Bal, W.; Wawrzyńska, A.; Kamińska, J.; Sirko, A. Effects of simultaneous expression of heterologous genes involved in phytochelatin biosynthesis on thiol content and cadmium accumulation in tobacco plants. J. Exp. Bot. 2006, 57, 2173–2182. [Google Scholar] [CrossRef]
- Guo, J.; Dai, X.; Xu, W.; Ma, M. Overexpressing GSH1 and AsPCS1 simultaneously increases the tolerance and accumulation of cadmium and arsenic in Arabidopsis thaliana. Chemosphere 2008, 72, 1020–1026. [Google Scholar] [CrossRef] [PubMed]
- Sharma, S.S.; Dietz, K.J. The significance of amino acids and amino acid-derived molecules in plant responses and adaptation to heavy metal stress. J. Exp. Bot. 2006, 57, 711–726. [Google Scholar] [CrossRef] [PubMed]
- Yuan, L.; Yang, S.; Liu, B.; Zhang, M.; Wu, K. Molecular characterization of a rice metal tolerance protein, OsMTP1. Plant Cell Rep. 2012, 31, 67–79. [Google Scholar] [CrossRef] [PubMed]
- Pál, M.; Janda, T.; Szalai, G. Interactions between plant hormones and thiol-related heavy metal chelators. Plant Growth Regul. 2018, 85, 173–185. [Google Scholar] [CrossRef]
- Fediuc, E.; Lips, S.H.; Erdei, L. O-acetylserine (thiol) lyase activity in Phragmites and Typha plants under cadmium and NaCl stress conditions and the involvement of ABA in the stress response. J. Plant Physiol. 2005, 162, 865–872. [Google Scholar] [CrossRef] [PubMed]
- Metwally, A.; Finkemeier, I.; Georgi, M.; Dietz, K.J. Salicylic Acid Alleviates the Cadmium Toxicity in Barley Seedlings1. Plant Physiol. 2003, 132, 272–281. [Google Scholar] [CrossRef] [PubMed]
- Freeman, J.L.; García, D.; Kim, D.; Hopf, A.; Salt, D.E. Constitutively Elevated Salicylic Acid Signals Glutathione-Mediated Nickel Tolerance in Thlaspi Nickel Hyperaccumulators1. Plant Physiol. 2005, 137, 1082–1091. [Google Scholar] [CrossRef] [PubMed]
- Bhalerao, S.; Sharma, A.; Poojari, A. Toxicity of Nickel in Plants. Int. J. Pure Appl. Biosci. 2015, 3, 345–355. [Google Scholar]
- Li, X.; Yang, Y.; Jia, L.; Chen, H.; Wei, X. Zinc-induced oxidative damage, antioxidant enzyme response and proline metabolism in roots and leaves of wheat plants. Ecotoxicol. Environ. Saf. 2013, 89, 150–157. [Google Scholar] [CrossRef]
- Guo, H.; Luo, S.; Chen, L.; Xiao, X.; Xi, Q.; Wei, W.; Zeng, G.; Liu, C.; Wan, Y.; Chen, J.; et al. Bioremediation of heavy metals by growing hyperaccumulaor endophytic bacterium Bacillus sp. L14. Bioresour. Technol. 2010, 101, 8599–8605. [Google Scholar] [CrossRef]
- Syranidou, E.; Christofilopoulos, S.; Gkavrou, G.; Thijs, S.; Weyens, N.; Vangronsveld, J.; Kalogerakis, N. Exploitation of Endophytic Bacteria to Enhance the Phytoremediation Potential of the Wetland Helophyte Juncus acutus. Front. Microbiol. 2016, 7, 416. [Google Scholar] [CrossRef] [PubMed]
- Rajkumar, M.; Prasad, M.N.V.; Swaminathan, S.; Freitas, H. Climate change driven plant–metal–microbe interactions. Environ. Int. 2013, 53, 74–86. [Google Scholar] [CrossRef] [PubMed]
- Babu, A.G.; Shea, P.J.; Sudhakar, D.; Jung, I.B.; Oh, B.T. Potential use of Pseudomonas koreensis AGB-1 in association with Miscanthus sinensis to remediate heavy metal(loid)-contaminated mining site soil. J. Environ. Manag. 2015, 151, 160–166. [Google Scholar] [CrossRef] [PubMed]
- Wan, Y.; Luo, S.; Chen, J.; Xiao, X.; Chen, L.; Zeng, G.; Liu, C.; He, Y. Effect of endophyte-infection on growth parameters and Cd-induced phytotoxicity of Cd-hyperaccumulator Solanum nigrum L. Chemosphere 2012, 89, 743–750. [Google Scholar] [CrossRef] [PubMed]
- Zhang, X.; Li, C.; Nan, Z. Effects of cadmium stress on growth and anti-oxidative systems in Achnatherum inebrians symbiotic with Neotyphodium gansuense. J. Hazard. Mater. 2010, 175, 703–709. [Google Scholar] [CrossRef] [PubMed]
- Ma, Y.; Oliveira, R.S.; Nai, F.; Rajkumar, M.; Luo, Y.; Rocha, I.; Freitas, H. The hyperaccumulator Sedum plumbizincicola harbors metal-resistant endophytic bacteria that improve its phytoextraction capacity in multi-metal contaminated soil. J. Environ. Manag. 2015, 156, 62–69. [Google Scholar] [CrossRef] [PubMed]
- Taghavi, S.; van der Lelie, D.; Hoffman, A.; Zhang, Y.B.; Walla, M.D.; Vangronsveld, J.; Newman, L.; Monchy, S. Genome sequence of the plant growth promoting endophytic bacterium Enterobacter sp. 638. PLoS Genet. 2010, 6, e1000943. [Google Scholar] [CrossRef]
- Gupta, K.; Chatterjee, C.; Gupta, B. Isolation and characterization of heavy metal tolerant Gram-positive bacteria with bioremedial properties from municipal waste rich soil of Kestopur canal (Kolkata), West Bengal, India. Biologia 2012, 67, 827–836. [Google Scholar] [CrossRef]
- El-Deeb, B. Plasmid Mediated Tolerance and Removal of Heavy Metals by Enterobacter sp. Am. J. Biochem. Biotechnol. 2009, 5, 47–53. [Google Scholar] [CrossRef][Green Version]
- Khan, A.L.; Waqas, M.; Kang, S.M.; Al-Harrasi, A.; Hussain, J.; Al-Rawahi, A.; Al-Khiziri, S.; Ullah, I.; Ali, L.; Jung, H.Y.; et al. Bacterial endophyte Sphingomonas sp. LK11 produces gibberellins and IAA and promotes tomato plant growth. J. Microbiol. 2014, 52, 689–695. [Google Scholar] [CrossRef]
- Khan, M.A.; Asaf, S.; Khan, A.L.; Ullah, I.; Ali, S.; Kang, S.M.; Lee, I.J. Alleviation of salt stress response in soybean plants with the endophytic bacterial isolate Curtobacterium sp. SAK1. Ann. Microbiol. 2019, 69, 797–808. [Google Scholar] [CrossRef]
- Patten, C.L.; Glick, B.R. Role of Pseudomonas putida Indoleacetic Acid in Development of the Host Plant Root System. Appl. Environ. Microbiol. 2002, 68, 3795–3801. [Google Scholar] [CrossRef] [PubMed]
- Schwyn, B.; Neilands, J. Universal chemical assay for the detection and determination of siderophores. Anal. Biochem. 1987, 160, 47–56. [Google Scholar] [CrossRef]
- Bose, B.; Katznelson, H. METABOLIC ACTIVITY AND PHOSPHATE-DISSOLVING CAPABILITY OF BACTERIAL ISOLATES FROM WHEAT ROOTS, RHIZOSPHERE, AND NON-RHIZOSPHERE SOIL. Can. J. Microbiol. 1959, 5, 79–85. [Google Scholar]
- Khan, A.R.; Ullah, I.; Waqas, M.; Park, G.S.; Khan, A.L.; Hong, S.J.; Ullah, R.; Jung, B.K.; Park, C.E.; Ur-Rehman, S.; et al. Host plant growth promotion and cadmium detoxification in Solanum nigrum, mediated by endophytic fungi. Ecotoxicol. Environ. Saf. 2017, 136, 180–188. [Google Scholar] [CrossRef] [PubMed]
- Sambrook, J.; Russell, D. Molecular Cloning: A Laboratory Manual, 3rd ed.; Cold Spring Harbor Laboratory Press: Cold Spring Harbor, NY, USA, 2001. [Google Scholar]
- Ullah, I.; Khan, A.R.; Park, G.S.; Lim, J.H.; Waqas, M.; Lee, I.J.; Shin, J.H. Analysis of phytohormones and phosphate solubilization in Photorhabdus spp. Food Sci. Biotechnol. 2013, 22, 25–31. [Google Scholar] [CrossRef]
- Eklund, B.I.; Edalat, M.; Stenberg, G.; Mannervik, B. Screening for recombinant glutathione transferases active with monochlorobimane. Anal. Biochem. 2002, 309, 102–108. [Google Scholar] [CrossRef]
- Rai, A.; Tripathi, P.; Dwivedi, S.; Dubey, S.; Shri, M.; Kumar, S.; Tripathi, P.K.; Dave, R.; Kumar, A.; Singh, R.; et al. Arsenic tolerances in rice (Oryza sativa) have a predominant role in transcriptional regulation of a set of genes including sulphur assimilation pathway and antioxidant system. Chemosphere 2011, 82, 986–995. [Google Scholar] [CrossRef] [PubMed]
- Zengin, F.K.; Munzuroglu, O. Effects of some heavy metals on content of chlorophyll, proline and some antioxidant chemicals in bean [Phaseolus vulgaris L.] seedlings. Acta Biol. Crac. Ser. Bot. 2005, 47, 157–164. [Google Scholar]
- Wood, C.W.; Reeves, D.W.; Himelrick, D.G. Relationships between chlorophyll meter readings and leaf chlorophyll concentration, N status, and crop yield: A review. Proc. Agron. Soc. N. Z. 1993, 23, 1–9. [Google Scholar]
- Finley-Jones, H.J.; Molloy, J.L.; Holcombe, J.A. Choosing internal standards based on a multivariate analysis approach with ICP(TOF)MS. J. Anal. At. Spectrom. 2008, 23, 1214–1222. [Google Scholar] [CrossRef]
- Spence, C.A.; Lakshmanan, V.; Donofrio, N.; Bais, H.P. Crucial Roles of Abscisic Acid Biogenesis in Virulence of Rice Blast Fungus Magnaporthe oryzae. Front. Plant Sci. 2015, 6, 1665. [Google Scholar] [CrossRef] [PubMed]
- Khan, M.A.; Ullah, I.; Waqas, M.; Hamayun, M.; Khan, A.L.; Asaf, S.; Kang, S.M.; Kim, K.M.; Jan, R.; Lee, I.J. Halo-tolerant rhizospheric Arthrobacter woluwensis AK1 mitigates salt stress and induces physio-hormonal changes and expression of GmST1 and GmLAX3 in soybean. Symbiosis 2019, 77, 9–21. [Google Scholar] [CrossRef]
- Seskar, M. Endogenous Methyl Salicylate in Pathogen-Inoculated Tobacco Plants. Plant Physiol. 1998, 116, 387–392. [Google Scholar] [CrossRef]
- Pavlík, M.; Pavlíková, D.; Zemanová, V.; Hnilička, F.; Urbanová, V.; Száková, J. Trace elements present in airborne particulate matter—Stressors of plant metabolism. Ecotoxicol. Environ. Saf. 2012, 79, 101–107. [Google Scholar] [CrossRef] [PubMed]
- Correia, M.J.; Fonseca, F.; Dias, C.; David, M.M.; Barrote, I.; Osório, M.L.; Osório, J.; Azedo-Silva, J.; Azedo-Silva, J. Effects of water deficit on the activity of nitrate reductase and content of sugars, nitrate and free amino acids in the leaves and roots of sunflower and white lupin plants growing under two nutrient supply regimes. Physiol. Plant. 2005, 124, 61–70. [Google Scholar] [CrossRef]
- Cataldo, D.A.; Garland, T.R.; Wildung, R.E. Cadmium Uptake Kinetics in Intact Soybean Plants. Plant Physiol. 1983, 73, 844–848. [Google Scholar] [CrossRef]
- Rosa, M.; Prado, C.; Podazza, G.; Interdonato, R.; Gonzalez, J.A.; Hilal, M.; Prado, F.E. Soluble sugars--metabolism, sensing and abiotic stress: A complex network in the life of plants. Plant Signal. Behav. 2009, 4, 388–393. [Google Scholar] [CrossRef]
- Singh, S.; Prasad, S.M. Growth, photosynthesis and oxidative responses of Solanum melongena L. seedlings to cadmium stress: Mechanism of toxicity amelioration by kinetin. Sci. Hortic. 2014, 176, 1–10. [Google Scholar] [CrossRef]
- Islam, M.M.; Hoque, M.A.; Okuma, E.; Banu, M.N.A.; Shimoishi, Y.; Nakamura, Y.; Murata, Y. Exogenous proline and glycinebetaine increase antioxidant enzyme activities and confer tolerance to cadmium stress in cultured tobacco cells. J. Plant Physiol. 2009, 166, 1587–1597. [Google Scholar] [CrossRef]
- Beesley, L.; Inneh, O.S.; Norton, G.J.; Moreno-Jiménez, E.; Pardo, T.; Clemente, R.; Dawson, J.J. Assessing the influence of compost and biochar amendments on the mobility and toxicity of metals and arsenic in a naturally contaminated mine soil. Environ. Pollut. 2014, 186, 195–202. [Google Scholar] [CrossRef] [PubMed]
- Siripan, O.; Thamchaipenet, A.; Surat, W. Enhancement of the efficiency of Cd phytoextraction using bacterial endophytes isolated from Chromolaena odorata, a Cd hyperaccumulator. Int. J. Phytoremediation 2018, 20, 1096–1105. [Google Scholar] [CrossRef] [PubMed]
- Vullo, D.L.; Ceretti, H.M.; Daniel, M.A.; Ramírez, S.A.; Zalts, A. Cadmium, zinc and copper biosorption mediated by Pseudomonas veronii 2E. Bioresour. Technol. 2008, 99, 5574–5581. [Google Scholar] [CrossRef]
- Truyens, S.; Jambon, I.; Croes, S.; Janssen, J.; Weyens, N.; Mench, M.; Carleer, R.; Cuypers, A.; Vangronsveld, J. The effect of long-term Cd and Ni exposure on seed endophytes of Agrostis capillaris and their potential application in phytoremediation of metal-contaminated soils. Int. J. Phytoremediation 2014, 16, 643–659. [Google Scholar] [CrossRef] [PubMed]
- Khan, N.; Bano, A. Role of plant growth promoting rhizobacteria and Ag-nano particle in the bioremediation of heavy metals and maize growth under municipal wastewater irrigation. Int. J. Phytoremediation 2016, 18, 211–221. [Google Scholar] [CrossRef] [PubMed]
- Yasin, N.A.; Khan, W.U.; Ahmad, S.R.; Ali, A.; Ahmad, A.; Akram, W. Effect of Enterobacter sp. CS2 and EDTA on the Phytoremediation of Ni-contaminated Soil by Impatiens balsamina. Pol. J. Environ. Stud. 2019, 28, 425–433. [Google Scholar] [CrossRef]
- Rubio, M.I.; Escrig, I.; Sanz, A. Cadmium and nickel accumulation in rice plants. Effects on mineral nutrition and possible interactions of abscisic and gibberellic acids. Plant Growth Regul. 1994, 14, 151–157. [Google Scholar] [CrossRef]
- Sirhindi, G.; Mir, M.A.; Abd-Allah, E.F.; Ahmad, P.; Gücel, S. Jasmonic Acid Modulates the Physio-Biochemical Attributes, Antioxidant Enzyme Activity, and Gene Expression in Glycine max under Nickel Toxicity. Front. Plant Sci. 2016, 7, 28. [Google Scholar] [CrossRef]
- Forman, H.J.; Zhang, H.; Rinna, A. Glutathione: overview of its protective roles, measurement, and biosynthesis. Mol. Asp. Med. 2009, 30, 1–12. [Google Scholar] [CrossRef]
- Hippeli, S.; Heiser, I.; Elstner, E.F. Activated oxygen and free oxygen radicals in pathology: New insights and analogies between animals and plants. Plant Physiol. Biochem. 1999, 37, 167–178. [Google Scholar] [CrossRef]
- Mullineaux, P.M.; Rausch, T. Glutathione, photosynthesis and the redox regulation of stress-responsive gene expression. Photosynth. Res. 2005, 86, 459–474. [Google Scholar] [CrossRef] [PubMed]
- Freeman, J.L.; Persans, M.W.; Nieman, K.; Albrecht, C.; Peer, W.; Pickering, I.J.; Salt, D.E. Increased Glutathione Biosynthesis Plays a Role in Nickel Tolerance in Thlaspi Nickel Hyperaccumulators. Plant Cell 2004, 16, 2176–2191. [Google Scholar] [CrossRef]
- Dixon, D.P.; Cummins, I.; Cole, D.J.; Edwards, R. Glutathione-mediated detoxification systems in plants. Curr. Opin. Plant Boil. 1998, 1, 258–266. [Google Scholar] [CrossRef]
- Howden, R. Cadmium-sensitive, cad1 mutants of Arabidopsis thaliana are phytochelatin deficient. Plant Physiol. 1995, 107, 1059–1066. [Google Scholar] [CrossRef] [PubMed]
- May, M.J.; Howden, R.; Rolls, B.; Cobbett, C.S. The glutathione-deficient, cadmium-sensitive mutant, cad2-1, of Arabidopsis thaliana is deficient in gamma-glutamylcysteine synthetase. Plant J. 1998, 16, 73–78. [Google Scholar]
- Zhu, Y.L.; Pilon-Smits, E.A.; Jouanin, L.; Terry, N. Overexpression of Glutathione Synthetase in Indian Mustard Enhances Cadmium Accumulation and Tolerance. Plant Physiol. 1999, 119, 73–80. [Google Scholar]
- Lee, K.; Bae, D.W.; Kim, S.H.; Han, H.J.; Liu, X.; Park, H.C.; Lim, C.O.; Lee, S.Y.; Chung, W.S. Comparative proteomic analysis of the short-term responses of rice roots and leaves to cadmium. J. Plant Physiol. 2010, 167, 161–168. [Google Scholar] [CrossRef]
- Ogawa, I.; Nakanishi, H.; Mori, S.; Nishizawa, N.K. Time course analysis of gene regulation under cadmium stress in rice. Plant Soil 2009, 325, 97–108. [Google Scholar] [CrossRef]
- Adamis, P.D.; Gomes, D.S.; Pinto, M.L.C.; Panek, A.D.; Eleutherio, E.C. The role of glutathione transferases in cadmium stress. Toxicol. Lett. 2004, 154, 81–88. [Google Scholar] [CrossRef]
- Molina, A.S.; Pedranzani, H.E.; Zirulnik, F.; Sandalio, L.M.; Pérez-Chaca, M.V.; Rodríguez-Serrano, M.; Romero-Puertas, M.C.; Pérez-Chaca, M.V.; Rodríguez-Serrano, M.; Romero-Puertas, M.C. Cadmium induces two waves of reactive oxygen species inGlycine max(L.) roots. Plant Cell Environ. 2014, 37, 1672–1687. [Google Scholar]
- Hao, F.; Wang, X.; Chen, J. Involvement of plasma-membrane NADPH oxidase in nickel-induced oxidative stress in roots of wheat seedlings. Plant Sci. 2006, 170, 151–158. [Google Scholar] [CrossRef]
- Anuradha, K.; Agarwal, S.; Rao, Y.V.; Rao, K.V.; Viraktamath, B.C.; Sarla, N. Mapping QTLs and candidate genes for iron and zinc concentrations in unpolished rice of MadhukarxSwarna RILs. Gene 2012, 508, 233–240. [Google Scholar] [CrossRef]
- Steffens, J.C.; Hunt, D.F.; Williams, B.G. Accumulation of non-protein metal-binding polypeptides (gamma-glutamyl-cysteinyl)n-glycine in selected cadmium-resistant tomato cells. J. Boil. Chem. 1986, 261, 13879–13882. [Google Scholar]
- DalCorso, G.; Farinati, S.; Furini, A. Regulatory networks of cadmium stress in plants. Plant Signal. Behav. 2010, 5, 663–667. [Google Scholar] [CrossRef]
- Czerpak, R.; Piotrowska, A.; Szulecka, K. Jasmonic acid affects changes in the growth and some components content in alga Chlorella vulgaris. Acta Physiol. Plant. 2006, 28, 195–203. [Google Scholar] [CrossRef]
- Braud, A.; Jézéquel, K.; Vieille, E.; Tritter, A.; Lebeau, T. Changes in Extractability of Cr and Pb in a Polycontaminated Soil After Bioaugmentation With Microbial Producers of Biosurfactants, Organic Acids and Siderophores. Water Air Soil Pollut. Focus 2006, 6, 261–279. [Google Scholar] [CrossRef]
- Abd, E.R.R.E.S.; Sobhy, E.E.; Perihan, S.A. Uptake of some heavy metals by metal resistant Enterobacter sp. isolate from Egypt. Afr. J. Microbiol. Res. 2013, 7, 2875–2884. [Google Scholar] [CrossRef]
- Płociniczak, T.; Sinkkonen, A.; Romantschuk, M.; Piotrowska-Seget, Z. Characterization of Enterobacter intermedius MH8b and its use for the enhancement of heavy metals uptake by Sinapis alba L. Appl. Soil Ecol. 2013, 63, 1–7. [Google Scholar] [CrossRef]
- Alam, M.Z.; Ahmad, S. Multi-metal biosorption and bioaccumulation by Exiguobacterium sp. ZM-2. Ann. Microbiol. 2013, 63, 1137–1146. [Google Scholar] [CrossRef]
- Monni, S.; Uhlig, C.; Hansen, E.; Magel, E. Ecophysiological responses of Empetrum nigrum to heavy metal pollution. Environ. Pollut. 2001, 112, 121–129. [Google Scholar] [CrossRef]
- Shahzad, R.; Khan, A.L.; Bilal, S.; Waqas, M.; Kang, S.M.; Lee, I.J. Inoculation of abscisic acid-producing endophytic bacteria enhances salinity stress tolerance in Oryza sativa. Environ. Exp. Bot. 2017, 136, 68–77. [Google Scholar] [CrossRef]
- Miura, K.; Okamoto, H.; Okuma, E.; Shiba, H.; Kamada, H.; Hasegawa, P.M.; Murata, Y. SIZ1 deficiency causes reduced stomatal aperture and enhanced drought tolerance via controlling salicylic acid-induced accumulation of reactive oxygen species in Arabidopsis. Plant J. Cell Mol. Biol. 2013, 73, 91–104. [Google Scholar] [CrossRef]
- Chettri, M.; Sawidis, T. Impact of Heavy Metals on Water Loss from Lichen Thalli. Ecotoxicol. Environ. Saf. 1997, 37, 103–111. [Google Scholar] [CrossRef]
- Asaf, S.; Hamayun, M.; Khan, A.L.; Waqas, M.; Khan, M.A.; Jan, R.; Lee, I.J.; Hussain, A. Salt tolerance of Glycine max L induced by endophytic fungus Aspergillus flavus CSH1, via regulating its endogenous hormones and antioxidative system. Plant Physiol. Biochem. 2018, 128, 13–23. [Google Scholar]
- Lee, S.C.; Luan, S. ABA signal transduction at the crossroad of biotic and abiotic stress responses. Plant Cell Environ. 2012, 35, 53–60. [Google Scholar] [CrossRef]
- Poschenrieder, C.; Gunse, B.; Barceló, J. Influence of Cadmium on Water Relations, Stomatal Resistance, and Abscisic Acid Content in Expanding Bean Leaves. Plant Physiol. 1989, 90, 1365–1371. [Google Scholar] [CrossRef]
- Saradhi, P.P. Proline Accumulation Under Heavy Metal Stress. J. Plant Physiol. 1991, 138, 554–558. [Google Scholar]
- Sziderics, A.H.; Rasche, F.; Trognitz, F.; Sessitsch, A.; Wilhelm, E. Bacterial endophytes contribute to abiotic stress adaptation in pepper plants (Capsicum annuum L.). Can. J. Microbiol. 2007, 53, 1195–1202. [Google Scholar] [CrossRef]
- Dhir, B.; Nasim, S.; Samantary, S.; Srivastava, S. Assessment of Osmolyte Accumulation in Heavy Metal Exposed Salvinia natans. Int. J. Bot. 2012, 8, 153–158. [Google Scholar]
- Islam, F.; Yasmeen, T.; Arif, M.S.; Riaz, M.; Shahzad, S.M.; Imran, Q.; Ali, I. Combined ability of chromium (Cr) tolerant plant growth promoting bacteria (PGPB) and salicylic acid (SA) in attenuation of chromium stress in maize plants. Plant Physiol. Biochem. 2016, 108, 456–467. [Google Scholar] [CrossRef]
- John, R.; Ahmad, P.; Gadgil, K.; Sharma, S. Effect of cadmium and lead on growth, biochemical parameters and uptake in Lemna polyrrhiza L. Plant Soil Environ. 2008, 54, 262–270. [Google Scholar] [CrossRef]
- Ahmad, P.; Sharma, S.; Srivastava, P.S. Differential physio-biochemical responses of high yielding varieties of mulberry (Morus alba) under alkalinity (Na2CO3) stress in vitro. Physiol. Mol. Biol. Plants 2006, 12, 59–66. [Google Scholar]

| Gene Name | Sequence (5′-3′) | Accession Number |
|---|---|---|
| OsGST-F | ATGGCGGCGGCGGAGAAGACGAA | XM_015764302 |
| OsGST-R | TCAGGATGAAGGTGCATCTGGTTGG | |
| OsMTP1-F | ATGGACAGCCATAACTCAGCACCTCCCC | XM_015784797 |
| OsMTP1-R | CTACTCGCGCTCAATCTGAATGGTTC | |
| OsPCS1-F | ATGCGATGCACATTCCCTTTGC | LC192427 |
| OsPCS1-R | TTAGCATTGTTCCCAAGGTTGTGG |
© 2019 by the authors. Licensee MDPI, Basel, Switzerland. This article is an open access article distributed under the terms and conditions of the Creative Commons Attribution (CC BY) license (http://creativecommons.org/licenses/by/4.0/).
Share and Cite
Jan, R.; Khan, M.A.; Asaf, S.; Lubna; Lee, I.-J.; Kim, K.M. Metal Resistant Endophytic Bacteria Reduces Cadmium, Nickel Toxicity, and Enhances Expression of Metal Stress Related Genes with Improved Growth of Oryza Sativa, via Regulating Its Antioxidant Machinery and Endogenous Hormones. Plants 2019, 8, 363. https://doi.org/10.3390/plants8100363
Jan R, Khan MA, Asaf S, Lubna, Lee I-J, Kim KM. Metal Resistant Endophytic Bacteria Reduces Cadmium, Nickel Toxicity, and Enhances Expression of Metal Stress Related Genes with Improved Growth of Oryza Sativa, via Regulating Its Antioxidant Machinery and Endogenous Hormones. Plants. 2019; 8(10):363. https://doi.org/10.3390/plants8100363
Chicago/Turabian StyleJan, Rahmatullah, Muhammad Aaqil Khan, Sajjad Asaf, Lubna, In-Jung Lee, and Kyung Min Kim. 2019. "Metal Resistant Endophytic Bacteria Reduces Cadmium, Nickel Toxicity, and Enhances Expression of Metal Stress Related Genes with Improved Growth of Oryza Sativa, via Regulating Its Antioxidant Machinery and Endogenous Hormones" Plants 8, no. 10: 363. https://doi.org/10.3390/plants8100363
APA StyleJan, R., Khan, M. A., Asaf, S., Lubna, Lee, I.-J., & Kim, K. M. (2019). Metal Resistant Endophytic Bacteria Reduces Cadmium, Nickel Toxicity, and Enhances Expression of Metal Stress Related Genes with Improved Growth of Oryza Sativa, via Regulating Its Antioxidant Machinery and Endogenous Hormones. Plants, 8(10), 363. https://doi.org/10.3390/plants8100363








